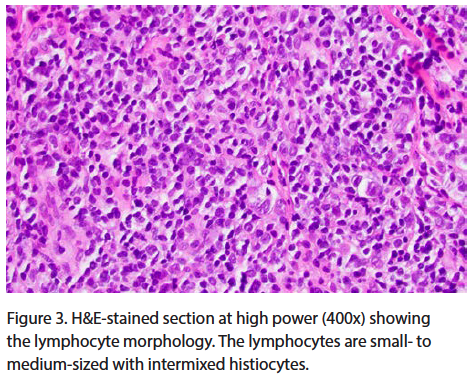
Figure 3

What Is This Papule?
Case Report

A 33-year-old woman presented to the clinic complaining of a “firm spot” on her left cheek that rapidly grew and stabilized over the course of approximately 6 weeks. The spot was solitary, and the patient was otherwise healthy. She denied any systemic symptoms or previous treatment to the area. On exam, there was a 6-mm, firm, brown to red papule on the left cheek (Figure 1). There was no palpable preauricular lymphadenopathy.
Scroll below to find out the answer!
Answer
Primary cutaneous CD4+ small/medium T-cell lymphoproliferative disorder (PCS-TCLPD) is a provisional subtype of peripheral T-cell lymphoma characterized by a solitary skin lesion with dense CD4+ small- to medium-sized pleomorphic T-cell infiltrates on histology and no prior or concurrent patches or plaques typical of mycosis fungoides.1 Previously referred to as “primary cutaneous CD4+ small/medium T-cell lymphoma,” PCS-TCLPD was recently reclassified in 2016 by the World Health Organization due to its indolent and typically localized nature.2 PCS-TCLPD accounts for 2% to 3% of primary cutaneous lymphomas, but more recent data from Dutch and Austrian cutaneous lymphoma registries suggest it may be as high as 6%.1,3
Clinical Presentation

PCS-TCLPD typically presents as a slow-growing, solitary erythematous or violaceous papule, plaque, nodule, or tumor often located on the head, neck, and upper trunk.4 However, it may present as multiple lesions.5 Rarely, ulceration is present.6 The lesions are often asymptomatic, but there are reports of tenderness and pruritis.4 The average age at presentation is between 50 and 60 years, but PCS-TCLPD can occur at any age, including in infants and children.6-9 PCS-TCLPD presents equally in women and men.10
Histology

On hematoxylin-eosin (H&E) stain, PCS-TCLPD is characterized by a dense, nodular to diffuse dermal infiltrate of CD4+ small- to medium-sized pleomorphic T lymphocytes (Figures 2 and 3). The infiltrate typically is within the dermis but may extend into the subcutis as well.2,3 Epidermotropism is not a prominent feature but may be focally present.10 The density of the infiltrate may cause effacement and destruction of adnexa and vasculature.4 Surface ulceration occurs in less than 10% of cases.4 Large pleomorphic cells may be present, but these make up less than 30% of the infiltrate. B cells, plasma cells, histiocytes, and eosinophils are also present in 70% to 80% of cases.4 Perifollicular and periadnexal granulomatous inflammation may also be seen.4
Immunophenotype
The majority of the cells are T lymphocytes expressing CD3 and CD4 (Figure 4). In most cases, the T lymphocytes are negative for CD8 and CD30.1 These cells also commonly express follicular helper T-cell markers such as PD-1, CXCL13, ICOS, and BCL-6.4 The Ki-67 proliferative index varies widely between cases but is usually between 5% and 30%.4

Genetic Findings
Molecular analysis demonstrated that 60% to 100% of cases have monoclonal TCR gene arrangements.4 No specific cytogenetic abnormalities or molecular alterations have been described.4 The lesions of PCS-TCLPD show no evidence of Epstein-Barr virus infection.4
Differential Diagnosis
The differential diagnosis includes primary cutaneous follicular helper T-cell lymphoma, tumor stage of mycosis fungoides, primary cutaneous marginal zone lymphoma, and primary cutaneous follicle center cell lymphoma. The Table summarizes the typical clinical presentation, histology, and immunophenotype for each diagnosis.4,11-15 PCS-TCLPD can look similar to many other entities on histology, so a careful consideration of the clinical presentation and immunophenotype must be taken into account.

Management
Diagnosis is typically made through careful clinicopathologic correlation. Small (<2 cm), well demarcated lesions can be removed by excisional biopsy. Larger lesions can be sampled by deep punch biopsies (≥4 mm) or incisional biopsies.16
Patients typically have an excellent prognosis with a 5-year survival rate of 100%.3,4 Treatment options include surgical excision, intralesional steroids, and radiation therapy.5,9 Two case reports have noted spontaneous resolution after biopsy, and the sites were monitored for recurrence.17,18 The lesions may recur after treatment, but this is rare.9 Staging is not recommended for these patients.3
Our Patient
Our patient underwent a diagnostic biopsy with a 4-mm punch biopsy. As of 4 months from the biopsy, the patient had no palpable growth at the biopsy site and no new lesions. Given the solitary lesion, we recommended annual skin exams and no additional treatment. She was referred to a local academic institution for a second opinion given the rare diagnosis.
Conclusion
PCS-TCLPD is a provisional subtype of peripheral T-cell lymphoma characterized by a solitary skin lesion with dense CD4+ small- to medium-sized pleomorphic T-cell infiltrates on histology and no prior or concurrent patches or plaques typical of mycosis fungoides.1 It typically presents as a slow-growing, solitary erythematous or violaceous papule, plaque, nodule or tumor often located on the head, neck, and upper trunk.4 Immunohistology is notable for CD3+, CD4+, CD8- T lymphocytes that often express follicular helper T-cell markers.4 Diagnosis is made through careful clinicopathologic correlation. Treatment involves surgical excision, which is typically curative.9 Staging is not recommended for these patients, and their prognosis is excellent with a 5-year survival rate of 100%.3-4
Affiliations
Dr Bennett will be a first-year dermatology resident at the University of Vermont in Burlington, VT, starting July 2022. She completed her internal medicine internship at Loyola University University Medical Center in Maywood, IL. Dr Napekoski is a pathologist/dermatopathologist with Edward-Elmhurst Health in Naperville, IL. Dr Lichon is a dermatologist and Mohs surgeron at DuPage Medical Group in Lombard, IL.


















